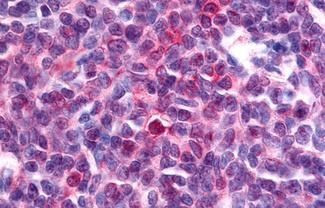
NOR-1 Antibody in Immunohistochemistry (Paraffin) (IHC (P))
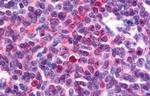
NOR-1 Antibody in Immunohistochemistry (Paraffin) (IHC (P))

Search
Invitrogen
NOR-1 Polyclonal Antibody
{{$productOrderCtrl.translations['antibody.pdp.commerceCard.promotion.promotions']}}
{{$productOrderCtrl.translations['antibody.pdp.commerceCard.promotion.viewpromo']}}
{{$productOrderCtrl.translations['antibody.pdp.commerceCard.promotion.promocode']}}: {{promo.promoCode}} {{promo.promoTitle}} {{promo.promoDescription}}. {{$productOrderCtrl.translations['antibody.pdp.commerceCard.promotion.learnmore']}}
产品信息
PA1-24536
宿主/亚型
分类
类型
抗原
偶联物
形式
浓度
规格
保存条件
运输条件
RRID
产品详细信息
PA1-24536 detects NOR-1 in Human samples.
靶标信息
NOR-1, a NR4 nerve growth factor-like receptor, has been shown to affect neuronal development, T-cell apoptosis, and cancer development. NOR-1 binds to NBRE (NGFI-B response element) and regulates the pro-opiomelanocortin (POMC) gene. NOR-1 is induced rapidly but transiently by a variety of stimuli. Downregulation of NOR-1 and other NGFI-B family members is correlated with drug addiction-prone behavior of Lewis rats. Three human protein isoforms have been documented: NOR-1, NOR-1beta, and NOR-1 3' variant.
仅用于科研。不用于诊断过程。未经明确授权不得转售。